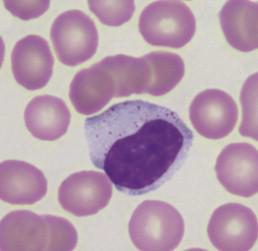

周琇珠 學校玻片
讀ross
postmortem
H base blue
E acid pink


9+2

stereocilia(男性生殖管內)

- basal lamina
- reticular lamina
上皮連上皮
- lamina densa (collagen fiber)
- lamina lucida
zonula:皮帶


細胞脫水可觀察
hemidesmosome:表皮連結締


[SimpleStratified][SquamousCuboidalColumnar]
- Pseudostratified Columnar
- Endothelium(內皮)
- Transitional (移形上皮)
- Mesothelium(間皮)
多層用最上層命名
- exocytosis
- 外分泌。通過胞吐作用,分泌細胞的任何部分都不會丟失。
- apocrine
- 大汗腺。細胞的頂端積累分泌物質,頂端被夾斷以釋放產物。 ex. 乳腺
- holocrine
- 全分泌。分泌細胞及其產物從基底膜脫落。ex. 皮脂腺

- 細胞核的形狀
- 角質層無細胞核
- 多層扁平與結締組織呈波浪狀
- Tansitional epi. 上層呈現立方

A:胚胎時期存在
- Fibroblast
- Macrophage (Histiocyte)
- Mast call
- Plasma
graph LR;
A[Extracellular matrix]-->B[Ground substance];
A[Extracellular matrix]-->C[Fibers];



- 最多
- Secreted by the fibroblasts
- type I collagen
- 光學顯微鏡下看不到橫紋,TEM下有
- 銀染下棕色
- type II collagen
- H&E下不被染,用Orcein, Aldehyde fuchsin staining,深紫
- TEM下無橫紋


- type III collagen
- black argyrophilia(銀染黑)
- 淋巴、血球、內分泌腺
graph LR;
a[CT proper]-->b[Loose CT]
a-->c[Dense CT]
c-->d[regular]
c-->e[irregular]
b-->f[Areolar tissue]
d-->g(tendons, ligament)
e-->h(membrane, capsules, dermis)
Dense CT |
Loose CT |
Fibroblast Collegen fiber(I) |
- |
- tendon 的 Fibroblast核拉長



- Perichondrium
- 軟骨膜,外層相似dense CT,內層分化
- Chondroblasts
- acting 類似Fibroblast

- Isogenic group
- chondrocyte 整群在中間
- Lacuna
- 軟骨窩(空白),chondrocyte脫水會露出
- 最多
- collegen(II)(和matrix折光差不多)
- lacuna 周圍較深,因為剛分泌出的proteoglycans 未和collegen(II)結合
- 因此matrix可分成perichondrim, interperichondrim region.

- hyaline + elastic fiber
- 耳殼、會厭軟骨

- 緩衝、耐張力
- 軟骨、dense CT之間
- 無Perichondrium
- collage(I)
- chondrocyte 排成一排
- Appositional
- Interstitial
Info
TEM下,合成 Fibrocartilage 的 condrocyte 有發達RER,合成hyaline,elastic有發達高基氏體

- periosteum
- 骨膜

- Osteocytes
- 伸出細胞質(Canaliculi),互相形成gap junction
- Osteoclasts
- 多核,roughly border 鄰骨頭(分泌H+)
- Osteoblasts
- periosteum下,Cuboidal


Info
維護Howship lacunae 酸性,侵蝕骨組織,再將Ca2+排到血液中

- Compact bone
- Lamellae (骨板)
- Circumferential lamellae
- Concentric lamellae
- Interstitial lamellae
- Osteons (骨單位 Haversian systems)
- Spongy (cancellous) bone
- Trabeculae (骨小梁)
- Spicules (骨小針)
Info
Osteons
- Concentric lamellae
- Central canal (BV, LV, nf.)
- Perforating (Volkmann’s) canal(橫向溝通)
- Canaliculi
- Lacunae (osteocyte)
begins by 8th
graph LR
og[Osteogenic]
ob[Osteoblasts]
ost[osteoid]
oc[Osteocytes]
ocl[Osteoclasts]
m[mesenchymal cell]-->p[periosteum]
og--分化-->ob--分泌-->ost
ob-->oc
ost--鈣質沈澱,包圍-->oc
monocytes--多個聚合-->ocl
- Intramembranous ossification
- 膜內骨化
- Endochondral ossification
- 軟骨內骨化
生成扁平骨

graph LR
O[ostoeblast]--分泌-->oo[Osteoid]-->c[鈣化]
O--四周-->2[Ostoeblast]
O--分化-->oc[Osteocytes]
m[mesenchymal cell]-->p[periosteum]
- mesenchymal cell
- 間葉細胞




- resting
- proliferation
- hypertrophic
- calcification
- ossification
- Epiphysis
- 生長板
加粗
需要 Osteoclast 加大骨髓腔

Info
Synovial membrane
type A
type B
- from mesenchymal cell
- 分泌潤滑
- 細扁
https://www.histologyguide.com/

from Mk cell(一半以上來自肺部)
胚胎時期

from 中胚層
mesenchymal cell → skeletal muscle

- epimysium (Deep fascia) = surrounds the whole muscle
- perimysium = surrounds fascicles
- fascicles
- 數十肌肉細胞束
- endomysium = separates individual muscle cells


Dark: A band
Light: I band

- myoglobin
- O2結合蛋白
- SER(sarcoplasmic reticulum)
- 存Ca2+

T tubule
: 細胞膜凹陷在AI junction,傳遞電位


|
Skeletal m. |
Cardiac m. |
Smooth m. |
核 |
多 |
1-2 |
1 |
玻片特徵 |
細胞核在邊緣,疏鬆 |
心間盤 |
長條細胞核 |
纖維 |
橫紋 |
橫紋 |
無橫紋 Dense body |
細胞質 |
myoglobin |
mitochondria |
- |
sarcoplasmic reticulum |
tubule triad |
tubule no triad |
no |
T-tube |
AI junction |
Z-line |
no |
傳遞 |
- |
gap j. |
caveolae (Ca2+) |

脂肪層外



Purkinje fibers
- Myocardium 的Actin, Myosin纖維被神經纖維(Myofilament)取代
- 比心肌細胞大
- 位於 Subendothelial
- 淺色,看不到fiber

白色空泡

黑色:心肌 白色: Purkinje fiber

Simple Squamous Epithelium


- endothelial
- Subendothelial
- Internal elastic lamina

- fibroblasts
- vasa vasorum(血管滋養管)
|
intima |
media |
adventitia |
|
endothelium |
subendothelial |
internal elastic membrane |
elastin |
smooth muscle |
externa elastic lamina |
fibroelastic CT |
vasa vasorum |
Elastic a. |
有 防凝血, Microphages |
有 |
不明顯 |
多 |
多 |
薄 |
薄 |
有 |
Muscular a. |
有 |
有 |
明顯 |
有 |
4-40 |
厚 |
厚 |
少 |
Small a./ Arterioles |
有 |
有 |
有 |
無 |
1-2 |
無 |
薄 |
無 |
Capillaries/ Postcapillary v. |
單層 |
無 |
無 |
無 |
pericyte |
無 |
無 |
無 |
Muscular v. |
有 |
無 |
無 |
無 |
1-2 |
無 |
薄 |
無 |
Medium v. |
有 |
- |
無 |
少 |
少 |
無 |
有 |
有 |
Large v. |
有 |
有 |
不明顯 |
薄 |
厚 |
有 |
特殊染色彈性纖維

彈性動脈內皮

透明帶: Elastin 圓核:Smooth m. 扁核:Fibroblast


Small arteries and Arterioles
elastin可見,外圍是1-2層平滑肌細胞



- continuous
- fenestrated
- 內皮細胞不含核的部分很薄
- 有許多貫穿細胞直徑一般為60~80nm孔洞
- 胃腸粘膜(lamina propria)
- 某些內分泌腺(Endocrine gland)
- 腎血管球(Kidney’s glomerulus)等處
- sinusoid(竇狀)

have valves
vasa vasorum


細胞用疊的,間格大


- Cisterna chvli
- 消化道淋巴匯集
- Capsule
- Afferent → Subscapular sinus → Trabecular sinuses → Medullary sinuses → Efferent



血管,淋巴細胞鑽出到germinal center 活化

Warning
In all lymphoid organ except the thymus
形成抗體
GC: Germinal center (產生抗體, B cell)
MnZ: Mantle zone(T cell)
粉紅色: Reticular cell

-
Pharyngeal tonsil
- Pseudostratified ciliated columnar epithelium
-
Palatine tonsils
-
Tonsilar fossa
-
Lingual tonsils
- 舌頭後上
- Stratified Squamous nonkeratined epithelium
-
Crypts
- nonkeratined
- 非角質化

位於黏膜層
位於消化器官
- 只有 efferent lymph vessel
- 無 lymphatic nodules
- 胸骨與主動脈弓之間
- CT(Capsule and Trabeculae)

Tip
明顯分頁

- Immature T cell
- epithelium reticular cell
Blood-thymus barrier

- 顏色較淡
- epithelium reticular cell
Hassall’s corpuscles
圍成同心圓的reticular cell


- fibrous capsule>trabeculae
- reticular fiber
- white pulp( Secondary lymphatic nodule)
- red pulp (other)


- central a. 被 T cell 包覆(Periarterial lymphatic sheath)
- Secondary lymphatic nodule

Central artery

Cell body
- 核大,核仁明顯
- rich rER & free ribosomes(called Nissl body)
- dendrite
- Axon
- Axon hillock(看不到nissl body)


- bipolar
- multi polar
- pseudounipolar
CNS





周圍空一圈
- 代謝、營養
- BBB(blood–brain barrier )



tunica fibrosa (纖維膜)
tunica vasculosa (血管膜)
- choroid
- 含黑色素吸光
- Bruch’s membrane(基底膜)
- 含血管,供應retina

tunica fibrosa (纖維膜)
tunica vasculosa (血管膜)
- ciliary body
- process+epithelium+muscle
- 製造 Aqueous(房水)
- iris(虹膜)

tunica nervosa
- retina
- pigmented layer
- Neural layer
- optic nerve & ora serrata

由外而內
- corneal epithelium
- Bowman’s membrane
- stroma
- Descemet’s membrane
- endothelium
ciliary body 伸出 zonular fibers 連接lens

外而內
- pigmented epithelium
- segment layer of rods and cones
- external limiting membrane
Visual cells(rods, cones)
-
outer nuclear layer
-
outer plexiform layer
Bipolar neurons
- inner nuclear layer
-
horizontal (橫走,整合)
-
Bipolar neurons
-
Amacrine cells (橫走,整合)
- inner plexiform layer
multipolar ganglion
-
ganglion cell layer
- multipolar ganglion cells
-
nerve fiber layer
Basal lamina

Optic disk

分泌黏性



Co:耳蝸
- outer : stratified squamous epi.
- between : collagen fibers, elastic fibers, fibroblast
- inner : simple cuboidal epi.

simple cuboidal epi. 組成
- Oval/vestibular window (卵圓窗)
Auditory ossicles
- Malleus
- Incus
- Stapes
- Cochlear/round window(圓窗)(多餘聲波)

- scala vestibuli(vestibular canal)
- scala media(cochlear duct)
- 內淋巴(duct外側壁的stria vascularis分泌)
- scala tympani(tympani canal)
|
Thick |
Thin |
Layer |
5 |
4 |
Sweet g. |
有 |
有 |
hair follicles |
無 |
有 |
sebaceous g. |
無 |
有 |
stratum lucidum 透明層 |
有 |
無 |
- stratum corneum
- stratum lucidum
- stratum granulosum
- 細胞核不明顯
- 顆粒染色 (keratohyalin granules)
- 準備細胞凋亡
- stratum spinosum
- stratum basale (germinativum)
- Papillay layer
- Reticular layer
腺體分類

- Infundibulum
- Isthmus
- Inferior segment


Duct cell 是複層鱗狀

- Non-keratinized Stratified Squamous Epi.
- Pseudostratified ciliated columnar epithelium with goblet cells
- Basal cell: stem cell
- Olfactory neurons: bipolar; Nuclei lie
- 聲門上:Stratified squamous nonkeratinized epithelium
- 聲門下:Pseudostratified ciliated columnar epithelium
軟骨類型
Cartilage |
Type |
Epiglottic |
elastic |
Thyroid |
hyaline |
Arytenoid |
elastic, hyaline |
Cricoid |
hyaline |
C-shape |
hyaline |
- Basement membrane 厚
- Goblet cells: 分泌黏液

- Clara cell: 無纖毛,圓頂,取代 Goblet cells
- 無軟骨
- Type II alveolar cell 立方狀,分泌表面張力素
- Dust cell 在 Pore


M simple squamous mesothelium
A alveoli
V blood vessel
L lymphatics






- Lining mucosa
- Masticatory mucosa
- Specialized mucosa


- secretory acini
- Mucous acini
- Serous acini
Serous semilunar

- ducts
- Intercalated duct
- Striated duct
- 粒線體明顯

- Excretory duct

- Intercalated duct 發達

Submandibular
- Striated duct 發達

- Excretory duct 發達


- Ameloblast 分泌 Enamel 最後消失

- Odontoblast 分泌 type I collage fiber, GAG,鈣化包住自己
- 形成 Dentinal tubules

- Cementum
- Periodontal ligament/ Sharpey fibers (collagen fibers )
- Alveolar bone with the associated gingiva
-
Proximal convoluted tubule (PCT)
-
Proximal straight tubule (PST)
-
Thin segment
-
Distal convoluted tubule (DCT)
-
Distal straight tubule (DST)

- Mucosa
- Muscularis
- Adventitia (外膜)




內而外
- Transitional epi.
- Stratified/ Pseudostratified columnar epi.
- Stratified squamous epi.

Intraepithelial gland
S:sinus
M:mucosa (Intraepithelial gland )


Littre gland
- 全在 lamina propria 裡面



- 約250 個小葉
- TA: Dense irregular

- Tunica (lamina) propria
- Wave of the seminiferous tubule
- 支持細胞
- 長核,淡染
- 核仁明顯(Karyosome)
- 血睪障壁(blood-testis barrier),阻擋免疫

細胞質會一直黏在一起
- Spermatogonia (SA, SB)
- Primary spermatocyte (S1)
- Spermatid (S3)
- Spermatozoa (S4)

- 柱狀 → 立方 → 扁平



- Pseudostratified epi
- Stererocilia
- Halo cell




Prostate Gland


- Peripheral zone
- Transitional zone
- Prostatic concretions (CA)
- 年輪狀,填在線體裡面

- Tunica albuginea (Deep fascia)
- Trabecular
- Penile Urethra

考試要寫分層
- Adventitia
- Outer longitudinal
- Circular layer
- Inner longitudinal














- Germinal epithelium
- Tunica albuginea
- Cortex
- Medulla
不成熟者靠外圍,較小

- follicle cells 包圍 只有一層 Simple squamous

- Simple cuboid 包圍
- 多層稱為 Stratum granulosum (顆粒層),細胞改稱 Granulosa cell
- Zona pellucida (透明帶)
- Cortical granules
- 精子進入後釋放激素,引發cortical reaction,破壞 zona pellucida 上的受體
- 出現空隙
Theca internal (TI)
- Theca external (TE)

- Cumulus oophorus (CO)
- Corona radiata (CR)

壞掉的
- Granulosa cell 掉落到空腔

- Zona pellucida (透明帶) 明顯 ,像洩氣氣球

- Theca lutein cell (TLC)
- 源於 Theca internal
- 深染,小顆密集
- Granulosa lutein cell (GLC)











- Mucosa
- Ciliated columnar epithelium (CC)
- Peg cell (PC 分泌)


- Epithelium
- Ciliated columnar epithelium
- 凹陷形成 Endometrium gland
- Endometrium
- Functional layer
- Basal layer
- Myometrium